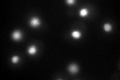
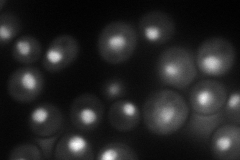
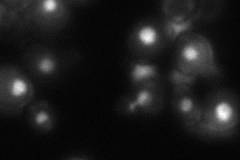
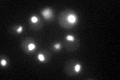

View description
Protein involved in the regulating Pol I and Pol II transcription, pre-mRNA processing, kinetochore function, and gene silencing; forms a complex with Spt5p
Localization:
Intensity:
Fold change:
Significance:
-
C’ GFP library in SD
nucleus85.12 -
N' NOP1pr-GFP in SD
nucleolus102.594 -
N' TEF2pr-mCherry in SD

nucleus114.603 -
N' NATIVEpr-GFP in SD
nucleus41.8458 -
N' TEF2pr-VC and Cyto-VN in SD

nucleus43.6512 -
C’ GFP library in SD+DTT

nucleus95.51.12No -
C’ GFP library in SD+H2O2

nucleus92.231.08No -
C’ GFP library in Starvation Media
nucleus95.51.12No -
C’ GFP library on the background of Pup2-DaMP

nucleus -
C’ GFP library on the background of CCT mutant

nucleus73.20780.859999No
